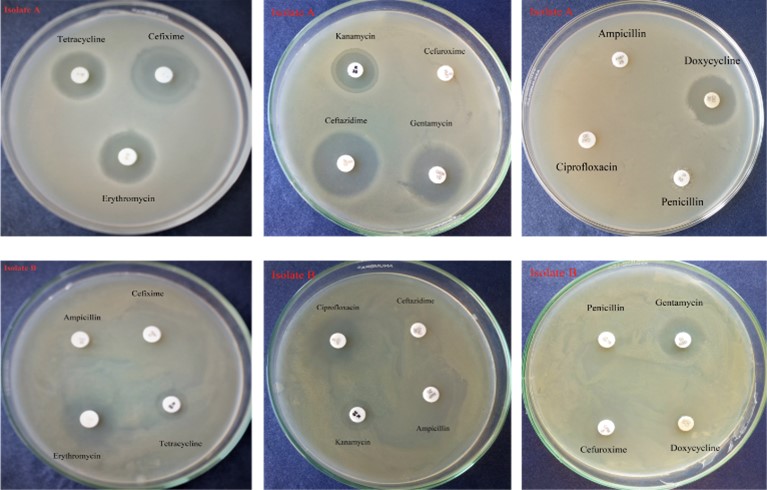
JabetEditor's tweet image. Isolation and #characterization of bacteria from two #soilsamples and their effect on #wheat (Triticum aestivum L.) #growthpromotion

doi.org/10.5455/jabet.…

#characterization hasil pencarian
Invited speakers dinner of #symposium ‘In Situ #Characterization During Thin-Film #Processing’ at the #F24MRS conference in #Boston

Some kids were ecstatic to see their masterpiece on the “Wow Work” Wall! 🥰 #TeamJordanJags #characterization
CRAFT + CONFIDENCE: K.C. Harper joined me to talk about and the one thing every story needs and how to handle rejection! buzzsprout.com/2031789/episod… #writingcommunity #amwriting #characterization @kcharper613

buzzsprout.com
53. Characters with Purpose and the Courage to Keep Writing | K.C....
When technology doesn't work on the 1st day of Module 1, great teaching still happens @MeadMS_AISD with teacher reading aloud & modeling to students how to infer about the character #TheCrossover #characterization Then, it's students' turn to do close reading with a partner.




Artificial intelligence for representing and characterizing quantum systems scirate.com/arxiv/2509.049… Efficient #characterization of large-scale quantum systems, especially those produced by quantum analog simulators and megaquop #quantumcomputers, poses a central challenge in…

📌New Paper📌 "Non-Pronominal Intransitive Verb Variants with Property Interpretation: A Characterization" by @feliu_elena Full Text: mdpi.com/2226-471X/8/4/… Related Special Issue: mdpi.com/journal/langua… #characterization #Spanish

#BookClub #Characterization in full swing. The conversations and excitement fill the classroom! #LearnersAtWork



Last week, Gimena Marin from @ICCRAM_UBU visited @IMDEA_Energia @EcpuEnergy to perform #electrochemical #characterization of battery materials in the framework of #MeBattery. A few samples are left at IMDEA for long-term ageing.

Not exactly #5amwritersclub, but I’ve been working on my story this morning. Went to bed thinking about my blueprint, #characterization, and the #worldbuilding. Got up w/ an idea to use juxtaposition & contrast to really make the story pop. #writing #writer #WritingCommunity

This week we have the pleasure to be part of the @UVA_EVcourse. A big thank you for the active participation in the #NTA training sessions, the interested discussions on #characterization of #EVs and the brilliant organization on site. #UVAEVWorkshop2025 @UVA #EVcharacterization




🚀 Introducing our new DAIR Green Fund Recipient: @Nord_Space and their cutting-edge project: #Performance #Characterization of SAFs in Liquid Bi-propellant #Rocket #Engines. 🔗 dairhub.com/initiatives/gr… The DAIR Green Fund, a program #supported through @FedDevOntario 🍁
#CARAC 2023 completed✅ Thanks to everyone who joined us today in Paris,it has been great to discuss and exchange with the #characterization community involving #industrialplayers, #endusers, #SMEs, #RIs & #tech organizations. The #STREAMLINETour will be back in 2024, #staytuned!




Submit your abstract by Nov 1 for the International Conference on Frontiers of Characterization and Metrology for Nanoelectronics (#FCMN2026) - March 16-19, 2026 in Monterey, CA #Nanoelectronics #Characterization #Metrology fcmn2026.avs.org conta.cc/4et5j5U

Collaborator Christiane Rahe et al. in Journal of The Electrochemical Society @ECSorg : "Multi-Method #Li #Plating #Characterization of a #Commercial #26Ah #Li-#Ion #Pouch-#Cell": iopscience.iop.org/article/10.114…
New Research Article🔬 "Non-destructive and deep learning-enhanced #characterization of 4H-SiC material" by Wenyu Kang & Jun Yin et al. @xmuchina @Wiley_Chemistry #crystal #surface #morphology Check👉doi.org/10.1002/agt2.5…

Searching for the top benchtop #SMU for easy and accurate #FET #characterization? See our solution and method in this application note! ow.ly/9MtK50PS2TR
ARTICLE PUBLISHED IN DYNA: COMPUTATIONAL #CHARACTERIZATION OF THE USE OF #HYDROGEN IN A BURNER NOWADAYS USING NATURAL GAS doi.org/10.6036/11063
#storytelling LINKS TO GOOD STORYTELLING #writing_stories #characterization #plot tom-gillispie.blogspot.com/2022/07/story.…
CRAFT + CONFIDENCE: K.C. Harper joined me to talk about and the one thing every story needs and how to handle rejection! buzzsprout.com/2031789/episod… #writingcommunity #amwriting #characterization @kcharper613

buzzsprout.com
53. Characters with Purpose and the Courage to Keep Writing | K.C....
Dendrimer in Cancer Treatment: A Review Read the Article here: bit.ly/3L9Fop9 #Application #Characterization #Dendrimer #Evaluation #Nanocarriers #Biomedical #Pharmacology #MedicalMicrobiology #ClinicalVirology #ClinicalEpidemiology #GeneticEpidemiology

Isolation and #characterization of bacteria from two #soilsamples and their effect on #wheat (Triticum aestivum L.) #growthpromotion doi.org/10.5455/jabet.…
🤗Glad to share this paper "Multiplex Bioanalytical #methods for Comprehensive #Characterization and Quantification of the Unique Complementarity-Determining-Region Deamidation of MEDI7247, an Anti-ASCT2 Pyrrolobenzodiazepine #Antibody–Drug Conjugate" mdpi.com/2073-4468/12/4…

🔬 Excited to share the publication "Approach to Standardized Material Characterization of the Human Lumbopelvic System: Testing and Evaluation"👉 mdpi.com/2306-5354/12/8… #material #characterization #standardization #human_pelvis #bone #bone #soft_tissue #fascia #ligaments

#characterization #mistakes #faults #failure #past #future #battles #definition #define #Jesus #Savior #Redeemer #purpose

🤗Glad to share this paper "Multiplex Bioanalytical #methods for Comprehensive #Characterization and Quantification of the Unique Complementarity-Determining-Region Deamidation of MEDI7247, an Anti-ASCT2 Pyrrolobenzodiazepine #Antibody–Drug Conjugate" mdpi.com/2073-4468/12/4…

Artificial intelligence for representing and characterizing quantum systems scirate.com/arxiv/2509.049… Efficient #characterization of large-scale quantum systems, especially those produced by quantum analog simulators and megaquop #quantumcomputers, poses a central challenge in…

Invited speakers dinner of #symposium ‘In Situ #Characterization During Thin-Film #Processing’ at the #F24MRS conference in #Boston

It's an honor that our research has been chosen for an oral presentation @AACR24 #Molecular #Characterization of #Colorectal #cancer in #Hispanics #Latinos #Genomics #Sequencing #Spatial #Transcriptomics #Ancestry #Diversity #PrecisionMedicine @PECGSnetwork @NCICRCHD @cityofhope

Nice #debate about #characterization and #management of small #renal masses during the @SIU_Italia #meeting at #AUA23. •Maybe not very bright future for #biopsy in this setting: #Imaging (MRI), #Radiomics and #ArtificialIntelligence will do the job. •Will reduced indication…



📌New Paper📌 "Non-Pronominal Intransitive Verb Variants with Property Interpretation: A Characterization" by @feliu_elena Full Text: mdpi.com/2226-471X/8/4/… Related Special Issue: mdpi.com/journal/langua… #characterization #Spanish

#BookClub #Characterization in full swing. The conversations and excitement fill the classroom! #LearnersAtWork



This week we read an excerpt from Rosa Parks autobiography. Today we used the acronym STEAL, collaboration, and vertical surfaces to analyze what she Says, Thinks, her Effects on others, her Actions, and what she Looks like. #characterization #Proud2BMIS

😍 #Book available for Special Issue: #Molecular #Characterization of #Gram-#Negative #Bacteria: #Antimicrobial #Resistance, #Virulence and #Epidemiology 😀 Edited by Dr. Theodoros Karampatakis 😇 Find this book at: mdpi.com/books/reprint/…

Submit your abstract by Nov 1 for the International Conference on Frontiers of Characterization and Metrology for Nanoelectronics (#FCMN2026) - March 16-19, 2026 in Monterey, CA #Nanoelectronics #Characterization #Metrology fcmn2026.avs.org conta.cc/4et5j5U

#mdpifoods #CoverArticle📔 🥚Title: #Characterization and Mechanism of Gel Deterioration of #Egg #Yolk Powder during #Storage by Yang Tian et al @LifesciMdpi 📌Link: mdpi.com/2304-8158/12/1…

#mdpifoods #Editor's Choice Article📔 🥰Title: Development and #Characterization of an Edible #Zein/Shellac Composite #Film Loaded with #Curcumin by Tao Han et al 📌Link: mdpi.com/2304-8158/12/8…

#PRBTopDownload: #Characterization and #experimental demonstration of corner states of boundary-obstructed #TopologicalInsulators in a #honeycomb lattice W.-J. Yang et al., Phys. Rev. B 107, 174101 – Published 1 May 2023 @APSPhysics #condmat #physics ➡️ go.aps.org/3O6e2zJ

🌲 #Forests🌲 New special issue is online: "Advances in #Wood #Characterization and in #Tree Sorting and Inspections: Insights from #Acoustic Testing and #Tomographic Imaging", guest edited by Raquel Gonçalves and Guillermo Íñiguez-González. 👉 mdpi.com/journal/forest…

Clinical #Characterization of a National Cohort of Patients With #Germline #WT1 Variants Including Late-Onset Phenotypes #VisualAbstract by @md_abdulqader83 kireports.org/article/S2468-…

#foodsmdpi Call for Papers📢 🔔Special Issue: "Advances in the #Detection, #Characterization and Reduction of #Mycotoxins in Food" Guest Editor: Dr. Leili Afsah-Hejri ⏰Deadline: 15 May 2025 📌Link: mdpi.com/journal/foods/…

Something went wrong.
Something went wrong.
United States Trends
- 1. Clay Higgins 21.2K posts
- 2. Grisham 3,237 posts
- 3. Scotland 48.3K posts
- 4. Peggy 6,525 posts
- 5. Dominguez 3,206 posts
- 6. Saudi 248K posts
- 7. Cashman N/A
- 8. #UNBarbie 14.3K posts
- 9. Bellinger 2,205 posts
- 10. Gemini 3 49.4K posts
- 11. Nicki 118K posts
- 12. Mary Bruce 4,436 posts
- 13. Khashoggi 50.4K posts
- 14. The House 553K posts
- 15. Tierney 4,670 posts
- 16. Shota 9,228 posts
- 17. Gleyber Torres 1,265 posts
- 18. Salman 78K posts
- 19. Woodruff 1,223 posts
- 20. #UnitedNationsBarbie 12.4K posts

























































































